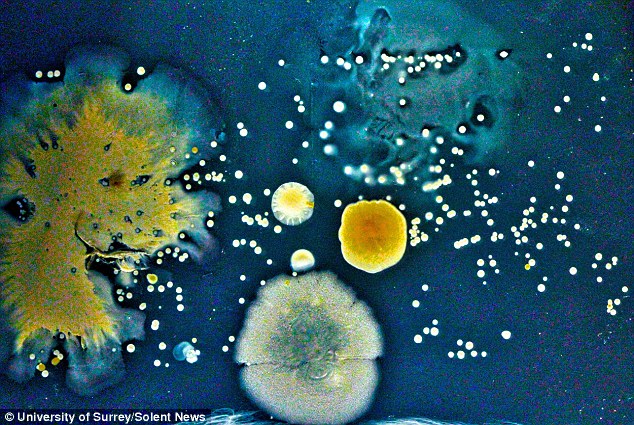
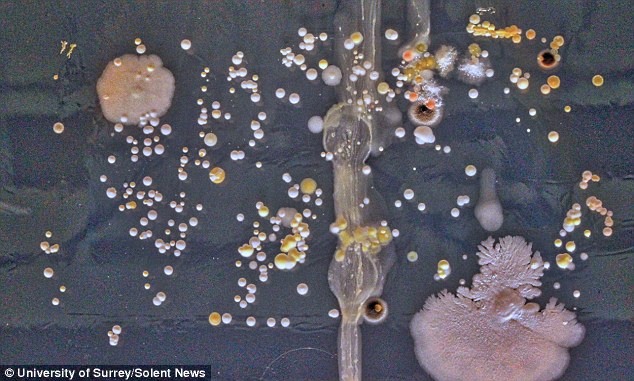

أخبارنا المغربية
كشفت دراسة علمية عن كارثة صحية بكل المقاييس خلال تعاملاتنا اليومية مع النقود، وذلك عبر تقرير مصور يبرز حجم المأساة.
وكانت صحيفة “ديلي ميل” البريطانية، قد سلطت الضوء على الدراسة وقالت” تبدو الصور كما لو كانت من وباء الطاعون، لكن الحقيقة أن هذه اللقطات تكشف مدى الأعداد المروعة للبكتيريا التي تنمو على المال”.
وأضافت” تم اكتشاف آلاف من مستعمرات البكتيريا على الأوراق النقدية والعملات المعدنية بعدما اختارها العلماء بشكل عشوائي التجربة تبرز مدى قذارة المال “.
وأردفت” قام العلماء بجمع المال من طلاب بجامعة ساري، ثم تم غمرها في “أجار”، وهي مادة التي تسمح للبكتيريا بالنمو سريعا وبعدها تم مراقبتها لمدة ثلاثة إلى أربعة أيام”.
واستطردت” وجد الطلاب آلاف من مستعمرات البكتيريا تعيش على الأموال، كما عثروا على بقع بكتيرية ما يشير على حمل المال لأمراض خطرة”.
وقالت” النوع الاكثر شيوعا من البكتيريا الذي اكتشف هو الفطر العصي وغير مؤذي، وهذا ما أكده الدكتور سيمون بارك، أحد كبار المحاضرين في علم الأحياء الجزيئي في الجامعة إذ قال:” الأنواع الأكثر شيوعا وجدت في بكتريا الجلد، لكن وجدت أنواع مثل MRSA التي تسبب التسمم الغذائي في دراسات أخرى ذات صلة”.
وأشارت إلى أن” العلماء وجودا حالات مصابة بالعنقوديات المذهبة يمكن أن تسبب الدمامل والبقع على الجلد، وهذا يشكل خطورة على من لديهم ضعف بجهاز المناعة، أو التي لا تكون في حالة الذروة مثل من هم بالمستشفيات”.
ولفتت الصحيفة إلى أن” حوالي 20 % من الناس يحملون البكتيريا في أنوفهم، ما يعني أن تكون مست أنوفهم قبل التعامل مع المال”.
ومن جانبه، قال الدكتور بارك: ” وجدنا أن المال سواء كان في القطع النقدية أو الورقية تؤوي أعدادا كبيرة جدا من البكتيريا، وهذه الأشياء تمر عبر العديد والعديد من الأيدي المختلفة مغسولة وغير مغسولة”.
وتابع” وضع المال في جيوب دافئة ورطبة، يهييء ظروف مثالية لنمو البكتيريا والبقاء على قيد الحياة، وبالتالي، فإن وجود البكتيريا على العملات يكون أكبر بكثير وأكثر تنوعا”.